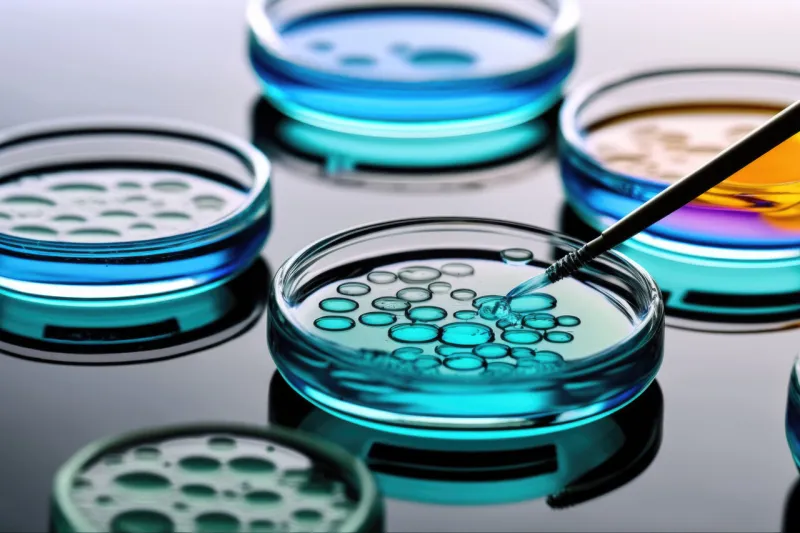
petri dishes medical lab generative ai

Pandémie : 6 virus qui pourraient ressurgir avec le réchauffement climatique

Incendies, sécheresses, canicules, tempêtes ou encore inondations… Les conséquences du réchauffement climatique sont fortement redoutées. Pourtant, les risques ne concernent pas seulement les intempéries et catastrophes naturelles. Les maladies et virus pourraient également se multiplier à cause du réchauffement climatique.
En effet, il est déjà responsable du dégel du pervirugélisol. Il s’agit d’une couche gelée, présente sous la surface de la Terre. En fondant, cette couche pourrait libérer des virus anciens ou inconnus et ainsi propager des maladies. Face à cette crainte, une équipe de chercheurs s’est réunie en début d’année afin de répertorier une liste de ces virus inquiétants. Leurs résultats ont été publiés dans la revue de virologie Viruses en février 2023.
Des virus zombies qui restent infectieux après plus de 48 500 ans
En janvier 2023, une équipe de chercheurs français, allemands et russes dirigée par Jean-Michel Claverie, professeur émérite à l'Université Aix Marseille, a publié une recherche pour lister les 6 zombies virus, âgés de 27 000 à 48 500 ans, qui pourraient revenir. Le terme zombie a été utilisé pour décrire ces virus en raison de leur capacité à revenir à la vie lorsqu’ils sont issus du pergélisol.
La plupart des virus isolés par les chercheurs appartenaient à la famille des pandoravirus. En effet, l'équipe ne s'est penchée que sur les virus qui infectent les amibes (organismes unicellulaires) car ils sont les plus inoffensifs. "Cette étude confirme la capacité des grands virus à ADN à rester infectieux après plus de 48 500 ans passés dans le pergélisol profond", concluent les auteurs. Pourtant, ils restent assez positifs pour le moment.
La situation serait plus grave en cas d’apparition d’un ancien virus inconnu
En effet, selon les chercheurs, comme ces virus sont des anciens virus connus, des traitements pourraient être mis en place pour les soigner, s’ils devaient recirculer à nouveau. "Nous pouvons raisonnablement espérer qu'une épidémie causée par une bactérie préhistorique réactivée pourrait rapidement être contrôlée par les antibiotiques modernes, même si les bactéries porteuses de gènes résistants aux antibiotiques semblent étonnamment répandues dans le pergélisol", expliquent les auteurs.
Selon eux, "la situation serait beaucoup plus désastreuse dans le cas de maladies végétales, animales ou humaines causées par la réapparition d'un ancien virus inconnu". En effet, dans ce cas précis il n’y aurait aucun traitement disponible immédiatement ce qui serait très dangereux. Medisite vous présente la liste des 6 virus zombies qui pourraient resurgir du pergélisol.
La souche de 1918 de la grippe

À la fin des années 1990, le pathologiste suédois, Dr Johan V. Hultin, a trouvé une souche d'ARN du virus de la grippe de 1918 dans les poumons d'une femme tuée par le virus près de 80 ans auparavant. La trace du virus avait été conservée afin de comprendre combien de temps il pouvait survivre dans le pergélisol arctique.
La variole

La variole est actuellement considérée comme éradiquée, le dernier cas ayant été détecté en 1977. Pourtant, en 2004, des scientifiques français et russes ont découvert ce virus à l’intérieur d’une momie sibérienne glacée de 300 ans.
Le Pithovirus sibéricum
Environ 7 fois plus gros qu’un virus moderne, le pithovirus a été redécouvert en 2014 dans les sols du nord-est de la Sibérie. Les scientifiques français du Centre national de la recherche scientifique de l'Université d'Aix-Marseille (CNRS-AMU) sont parvenus à ressusciter le Pithovirus sibericum zombie vieux de 30 000 ans. "C'est la première fois que nous voyons un virus encore infectieux après ce laps de temps", avait alors déclaré le professeur Claverie du CNRS-AMU.
Le Pacmanvirus lupus

Un ancien parent du virus de la peste porcine africaine, le Pacmanvirus lupus, a été découvert en train de dégeler dans les intestins d'un loup de Sibérie congelé, vieux de 27 000 ans.
Le mammouth Pandoravirus

Le pandoravirus a été découvert dans un amas de glace et de laine de mammouth congelé vieux de 27 000 ans sur les rives de la rivière Yana en Russie.
Le mammouth megavirus

Tout comme le mammouth Pandoravirus, le mammouth Megavirus a été découvert dans un amas de glace et de laine de mammouth congelé vieux de 27 000 ans sur les rives de la rivière Yana en Russie.